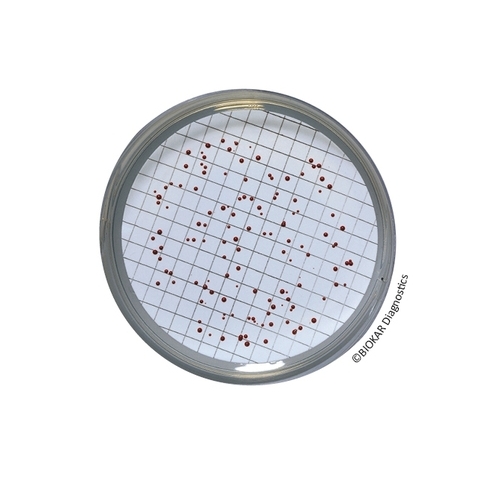
Slanetz and Bartley Agar

Slanetz and Bartley Agar
Slanetz and Bartley Agar is a selective medium used for the enumeration of intestinal enterococci in drinking water, beverages, waste water, swimming pool water and various biological products of animal origin, by the membrane filtration method.
| Ürün Adı | Slanetz and Bartley Agar (without TTC) |
| Ürün Kodu | BK129HA |
| Miktar | 500 g |
| Ürün Adı | Slanetz and Bartley Agar |
| Ürün Kodu | BS02708 |
| Miktar | 10 vials qsp 500 mL |
| Ürün Adı | Slanetz and Bartley Agar |
| Ürün Kodu | BM14608 |
| Miktar | 20 Petri plates Ø 55 mm |
| Ürün Adı | Slanetz and Bartley Agar |
| Ürün Kodu | BK037HA |
| Miktar | 500 g |
| Ürün Adı | Slanetz and Bartley Agar |
| Ürün Kodu | BM09408 |
| Miktar | 120 Petri plates Ø 55 mm |